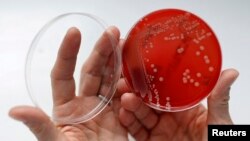
Ілюстрацыйнае фота

Новага інструмэнт штучнага інтэлекту (ШІ) усяго за два дні вырашыў складаную праблему, над якой мікрабіёлягі працавалі дзесяцігодзьдзе, паведамляе ВВС.
Прафэсар Хасэ Р. Пэнадэс і ягоная каманда ў Імпэрскім каледжы Лёндана патрацілі гады на вывучэньне таго, чаму некаторыя супэрбактэрыі ўстойлівыя да антыбіётыкаў. Калі навуковец вырашыў пратэставаць магчымасьці новага ШІ-інструмэнту і задаў яму ключавое пытаньне па сваёй тэме, сыстэма прапанавала гіпотэзу, ідэнтычную іх высновам.
Прафэсар даў «co-scientist» — новаму інструмэнту, створанаму Google — кароткую падказку, спытаўшы яго аб асноўнай праблеме, якую ён дасьледаваў, і ШІ прыйшоў да той жа высновы за 48 гадзін.
Прафэсар распавёў BBC, што быў агаломшаны такімі вынікамі, бо яго дасьледаваньні не публікаваліся ў адкрытым доступе. Ён нават напісаў у Google з пытаньнем, ці не атрымаў штучны інтэлект доступ да ягонага кампутара. Аднак кампанія запэўніла, што гэтага не адбылося.
Паводле Пэнадэса, штучны інтэлект ня проста паўтарыў ягоную гіпотэзу, але і прапанаваў чатыры дадатковыя тэорыі, усе зь якіх аказаліся лягічнымі. Адна зь іх была настолькі пэрспэктыўнай, што каманда прафэсара неадкладна пачала працу над ёй.
Дзесяцігодзьдзе, выдаткаванае навукоўцамі, таксама ўключае час, які спатрэбіўся для доказу гіпотэзы, што само па сабе заняло некалькі гадоў. Але навукоўцы кажуць, што калі б у іх была гіпотэза ў пачатку праекту, гэта зэканоміла б гады працы.
Дасьледчыкі спрабавалі высьветліць, як утвараюцца некаторыя супэрбактэрыі — небясьпечныя мікробы, устойлівыя да антыбіётыкаў.
Іх гіпотэза заключаецца ў тым, што супэрбактэрыі могуць утвараць хвост з розных вірусаў, што дазваляе ім распаўсюджвацца паміж відамі. Гэтая ідэя не была апублікаваная і ніхто з групы дасьледчыкаў не дзяліўся сваімі высновамі, але штучны інтэлект усё ж здолеў прыйсьці да аналягічнай высновы.
На думку навукоўцы, магчымасьці такіх інструмэнтаў кардынальна зьменяць навуку. Нягледзячы на асьцярогі, што штучны інтэлект можа замяніць чалавечую працу, ён упэўнены: гэта не пагроза, а магутны інструмэнт, які дазволіць значна паскорыць навуковыя адкрыцьці.

Форум